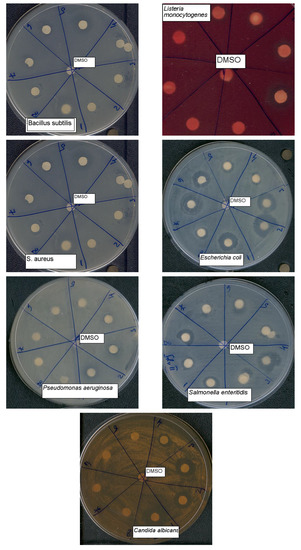
Molecules 13 00567 g001 550

Abstract
We report here the characterisation of eight newly synthesized thioureides of 2-(4-chlorophenoxymethyl)-benzoic acid and the evaluation of the in vitro antimicrobial activity of the new compounds against Gram-positive [Listeria monocytogenes, Staphylococcus aureus, Bacillus subtilis], Gram-negative [Psedomonas aeruginosa, Escherichia coli, Salmonella enteritidis], as well as Candida spp., using both reference and clinical multidrug resistant strains to establish the minimal inhibitory concentration (MIC) values. Our results showed that the tested compounds exhibited specific antimicrobial activities, both concerning the spectrum of antimicrobial activity and the corresponding MIC values, which ranged widely between 1024 and 32 μg/mL, depending on the nature and position of the substituents on the benzene ring. The most active compounds were N-[2-(4-chlorophenoxymethyl)-benzoyl]-N'-(2,6-dichlorophenyl)-thiourea (5g) and N-[2-(4-chlorophenoxymethyl)-benzoyl]-N'-(4-bromophenyl)-thiourea (5h), which showed a broad spectrum of antimicrobial activity against enterobacterial strains (E. coli and S. enteritidis), P. aeruginosa, S. aureus and Candida spp. All the tested compounds except 5f were highly active against S. aureus (MIC=32 μg/mL), suggesting their possible use in the treatment of MRSA infections. Four of compounds also exhibited antifungal activity (MIC =256-32 μg/mL) against C. albicans, but L. monocytogenes as well as B. subtilis were resistant to all tested compounds. Our studies thus demonstrated that among other biological activities, the thioureides of 2-(4-chlorophenoxymethyl)-benzoic acid also exhibit selective and effective antimicrobial properties that could lead to the selection and use of these compounds as efficient antimicrobial agents, especially for the treatment of multidrug resistant infections.
Introduction
Thioureides are associated with a broad spectrum of biological activities including antibacterial, antifungal, tuberculostatic, anthelmintic, antitumor, anticonvulsant, diuretic, insecticidal and pesticidal properties. In light of the therapeutical importance of some N-acylated thiourea derivates, especially as antibacterials and antifungals, we have evaluated the in vitro activity of some new thioureides derived from 2-(4-chlorophenoxymethyl)-benzoic acid. We have focused on a qualitative screening assay of the antimicrobial properties (adapted disk diffusion method), as well as a quantitative assay of the antimicrobial activity (binary microdilution method), to establish the minimal inhibitory concentration (MIC) values of these compounds against microbial Gram-positive, Gram-negative and fungal strains. We also studied the cytototoxicity of the tested compounds by flow cytometry and annexin V assay. In previous papers [1,2,3,4] we have presented the synthesis and characterization of some other thioureides of 2-phenoxymethylbenzoic acid, either unsubstituted or substituted with a methoxy or methyl group. We have now extended our research to the preparation and evaluation of the antimicrobial activity of some new thioureides of 2-(4-chlorophenoxymethyl)-benzoic acid. The reaction conditions, yields and some of the physical properties were established. NMR and IR spectral parameters and the elemental analysis have confirmed the structure of the synthesized compounds.
Results and Discussion
Synthesis
The synthesis of the new compounds was completed in three stages:
I. The synthesis of 2-(4-chlorophenoxymethyl)-benzoic acid (1)
The best yields in the synthesis of compound 1 were obtained when the intermediate compound used was the phthalide 2, which was treated with potassium p-chlorophenoxide in xylene under reflux.
This gives the potassium salt 3 of 2-(4-chlorophenoxymethyl)-benzoic acid, which has good solubility in 10% aqueous sodium hydroxide solution, allowing its facile separation from xylene. The acid 1 is then precipitated using a mineral acid solution. The potassium p-chlorophenoxide was obtained through the reaction of p-chlorophenol with potassium hydroxide in xylene. The resulting water was removed by azeotropic distillation. These reactions are presented in Scheme 1.

Scheme 1.
The synthesis of 2-(4-chlorophenoxymethyl)-benzoic acid (1).
Scheme 1.
The synthesis of 2-(4-chlorophenoxymethyl)-benzoic acid (1).

II. The synthesis of 2-(4-chloro-phenoxymethyl)-benzoyl chloride (4)
2-(4-Chlorophenoxymethyl)-benzoyl chloride (4) was prepared by refluxing acid 1 with thionyl chloride, using anhydrous 1,2-dichlorethane as reaction medium (Scheme 2).

Scheme 2.
The synthesis of 2-(4-chlorophenoxymethyl)-benzoyl chloride (4).
Scheme 2.
The synthesis of 2-(4-chlorophenoxymethyl)-benzoyl chloride (4).

III. The synthesis of the new thioureides 5a-h
The new compounds 5a-h were prepared by refluxing 2-(4-chlorophenoxymethyl)-benzoyl isothiocyanate (6) with primary aromatic amines in dry acetone. The isothiocyanate 6 was obtained through the reaction between 2-(4-chlorophenoxymethyl)-benzoyl chloride (4) and ammonium thiocyanate in dry acetone, as shown in Scheme 3. The isothiocyanate was not isolated and the appropriate amines were directly added to the reaction mixture to give the thioureides.

Figure 3.
The synthesis of the new thioureides 5a-h.
Figure 3.
The synthesis of the new thioureides 5a-h.

The new thioureides are white or light yellow crystalline solids, soluble at room temperature in acetone and chloroform, by heating in lower alcohols, benzene, toluene and xylene and insoluble in water. The structure, molecular formulae, molecular weights, melting points and yields of the new thioureides are presented in Table 1.

Table 1.
Characteristics of the new compounds. 

| No. | R | Molecular formula | Molecular weight | Melting point (0C) | Yield (%) |
|---|---|---|---|---|---|
| 5a | -C6H5 | C21H17ClN2O2S | 396.893 | 145.2- 147.6 | 64.3 |
| 5b | -C6H4CH3 (4) | C22H19Cl N2O2S | 410.913 | 135.7- 138.1 | 62.9 |
| 5c | -C6H4OCH3 (4) | C22H19ClN2O3S | 426.913 | 132.3- 135.4 | 69.4 |
| 5d | -C6H4Cl (4) | C21H16Cl2N2O2S | 431.336 | 154.8- 157.4 | 73.2 |
| 5e | -C6H3Cl2 (2,4) | C21H15Cl3N2O2S | 465.786 | 152.5- 155.0 | 71.6 |
| 5f | -C6H3Cl2 (2,5) | C21H15Cl3N2O2S | 465.786 | 152.6- 155.2 | 78.5 |
| 5g | -C6H3Cl2 (2,6) | C21H15Cl3N2O2S | 465.786 | 201.9- 204.6 | 65.7 |
| 5h | -C6H4Br (4) | C21H16ClBrN2O2S | 475.799 | 163.5- 165.2 | 75.3 |
The calculated formulae for the proposed structures were in good agreement with the elemental analysis results (Table 2).

Table 2.
Elemental analysis data.
 | |||||||||
|---|---|---|---|---|---|---|---|---|---|
| No. | R | C% | H% | N% | S% | ||||
| c. | e. | c. | e. | c. | e. | c. | e. | ||
| 5a. | -C6H5 | 63.49 | 63.36 | 4.28 | 4.25 | 7.05 | 6.99 | 8.06 | 7.94 |
| 5b. | -C6H4CH3 (4) | 64.24 | 63.99 | 4.62 | 4.60 | 6.81 | 6.78 | 7.78 | 7.82 |
| 5c. | -C6H4OCH3 (4) | 61.83 | 61.64 | 4.45 | 4.49 | 6.56 | 6.45 | 7.49 | 7.54 |
| 5d. | -C6H4Cl (4) | 58,42 | 58.70 | 3.70 | 3.70 | 6.49 | 6.37 | 7.42 | 7.41 |
| 5e. | -C6H3Cl2 (2,4) | 54.10 | 54.20 | 3.22 | 3.24 | 6.01 | 5.97 | 6.87 | 6.70 |
| 5f. | -C6H3Cl2 (2,5) | 54.10 | 54.03 | 3.22 | 3.29 | 6.01 | 5.92 | 6.87 | 6.71 |
| 5g. | -C6H3Cl2 (2,6) | 54.10 | 54.09 | 3.22 | 3.18 | 6.01 | 5.99 | 6.87 | 6.82 |
| 5h. | -C6H4Br (4) | 52.96 | 52.64 | 3.36 | 3.29 | 5.88 | 5.76 | 6.72 | 6.65 |
c = calculated; e = experimental
Spectral data
All new compounds were characterized by 1H- and 13C-NMR and IR spectroscopy. The 1H-NMR spectral values (δ, ppm, J, Hz) for the new compounds are presented in Table 3. In Table 4, we present the 13C-NMR assigments for the new thioureides. The caracteristic IR bands (cm-1) for the 2-(4-chloro-phenoxymethyl)-benzoic acid thioureides are presented in Table 5.

Table 3.
1H-NMR data (δ, ppm, J, Hz).
 | ||||||||||||||
|---|---|---|---|---|---|---|---|---|---|---|---|---|---|---|
| R | H4- H7 | H8 | H10 | H11 | H13 | H14 | H17 | H18 | H19 | H20 | H21 | -NH- | ||
| -OCH3 | ||||||||||||||
 | 7.28- 7.68 m | 5.32 s | 7.01 d (7.9) | 7.30 d (7.9) | 7.30 d (7.9) | 7.01 d (7.9) | 7.28- 7.68 m | 7.28- 7.68 m | 7.28- 7.68 m | 7.28- 7.68 m | 7.28- 7.68 m | 11.84 s 12.40 s | - | |
 | 7.56- 7.62 m | 5.30 s | 7.31 d (8.9) | 7.00 d (9.0) | 7.00 d (9.0) | 7.31 d (8.9) | 7.45 d (8.6) | 7.20 d (8.2) | - | 7.20 d (8.2) | 7.45 d (8.6) | 11.79 s l12.33 sl | ||
 | 7.45- 7.66 m | 5.31 s | 7.02 d (8.9) | 7.46 d (9.0) | 7.46 d (9.0) | 7.02 d (8.9) | 7.32 d (8.8) | 6.96 d (8.8) | - | 6.96 d (8.8) | 7.32 d (8.8) | 11.79 s 12.26 s | ||
| 3.77 s | ||||||||||||||
 | 7.42- 7.63 m | 5.32 s | 7.00 d (9.0) | 7.30 d (9.0) | 7.30 d (9.0) | 7.00 d (9.0) | 7.46 d (8.8) | 7.62 d (8.8) | - | 7.62 d (8.8) | 7.46 d (8.8) | 11.90 s 12.38 s | - | |
 | 7.42- 7.68 m | 5.30 s | 6.99 d (9.1) | 7.30 d (9.1) | 7.30 d (9.1) | 6.99 d (9.1) | - | 7.73 d (2.3) | - | 7.81 dd (8.8; 2.3) | 7.96 d (8.8) | 12.12 s 12.43 s | - | |
 | 7.40- 7.70m | 5.30 s | 7.01 d (8.9) | 7.28 d (8.9) | 7.28 d (8.9) | 7.01 d (8.9) | - | 7.40-7.70 m | 7.39 dd (8.9; 2.6) | - | 8.11 d (2.6) | 12.16 s 12.53 s | - | |
 | 7.42-7.62 m | 5.28 s | 7.00 d (8.9) | 7.32 d (8.9) | 7.32 d (8.9) | 7.00 d (8.9) | - | 7.54 d (8.0) | 7.37 dd (8.0; 7.4) | 7.54 d (8.0) | - | 11.05 s 11.39 s | - | |
 | 7.45- 7.70 m | 5.34 s | 7.00 d (8.9) | 7.31 d (8.9) | 7.31 d (8.9) | 7.00 d (8.9) | 7.57 s | 7.57 s | - | 7.57 s | 7.57 s | 11.89 s 12.37 s | - | |

Table 4.
13C-NMR data (δ, ppm).
 | |||||||
|---|---|---|---|---|---|---|---|
| R |  |  |  |  | |||
| C1 | 169.57 | 170.05 | 170.02 | 169.98 | |||
| C2 | 134.99 | 131.04 | 133.37 | 131.1 | |||
| C3 | 137.64 | 135.64 | 135.24 | 136.8 | |||
| C4 | 127.56 | 124.19 | 127.9 | 126.1 | |||
| C5 | 133.10 | 129.22 | 131.05 | 133.3 | |||
| C6 | 128.26 | 128.41 | 128.56 | 127.9 | |||
| C7 | 128.17 | 127.88 | 128.44 | 127.9 | |||
| C8 | 67.73 | 67.79 | 67.8 | 67,82 | |||
| C9 | 156.83 | 157.0 | 157.05 | 157.03 | |||
| C10 | 116.37 | 116.44 | 116.50 | 116,49 | |||
| C11 | 130.73 | 129.05 | 129.25 | 129.3 | |||
| C12 | 125,9 | 124.68 | 125.9 | 128.5 | |||
| C13 | 130.73 | 129.05 | 129.25 | 129.3 | |||
| C14 | 116.37 | 116.44 | 116.50 | 116,49 | |||
| C15 | 178.65 | 178.83 | 179.05 | 179.18 | |||
| C16 | 134.9 | 135.22 | 130.7 | 135.3 | |||
| C17 | 123.77 | 124.09 | 124.74 | 124.7 | |||
| C18 | 128.88 | 128.55 | 113.78 | 128.4 | |||
| C19 | 124.58 | 133.32 | 157.44 | 130.2 | |||
| C20 | 128.88 | 128.55 | 113.78 | 128.4 | |||
| C21 | 123.77 | 124.09 | 124.74 | 124.7 | |||
| - | - | ||||||
| -OCH3 | 55.30 | ||||||
| R |  |  |  |  | |||
| C1 | 170.11 | 170.32 | 169.50 | 169.98 | |||
| C2 | 133.29 | 131.19 | 133.14 | 133.23 | |||
| C3 | 135.33 | 135.25 | 134.93 | 137.25 | |||
| C4 | 128.56 | 128.05 | 128.18 | 127.90 | |||
| C5 | 131.37 | 131.10 | 130.86 | 131.46 | |||
| C6 | 128.76 | 128.69 | 128.29 | 128.58 | |||
| C7 | 128.69 | 128.65 | 128.69 | 128.44 | |||
| C8 | 68.13 | 67.94 | 67.79 | 67.80 | |||
| C9 | 157.13 | 157.01 | 156.83 | 157.02 | |||
| C10 | 116.66 | 116.41 | 116.45 | 116.48 | |||
| C11 | 129.26 | 129.20 | 128.9 | 129.24 | |||
| C12 | 127.95 | 127.71 | 127.78 | 126.41 | |||
| C13 | 129.26 | 129.20 | 128.9 | 129.24 | |||
| C14 | 116.66 | 116.41 | 116.45 | 116.48 | |||
| C15 | 180.12 | 179.95 | 180.51 | 179.10 | |||
| C16 | 134.60 | 136.5 | 133.53 | 135.3 | |||
| C17 | 128.91 | 126.88 | 127.88 | 124.73 | |||
| C18 | 129.17 | 130.78 | 129.46 | 131.13 | |||
| C19 | 131.14 | 126.99 | 128.18 | 118.49 | |||
| C20 | 127.27 | 133.22 | 129.46 | 131.13 | |||
| C21 | 124.93 | 124.74 | 124.58 | 124.73 | |||
| - | - | - | - | ||||
| -OCH3 | |||||||

Table 5.
IR data for the new compounds.
 | |||||||
|---|---|---|---|---|---|---|---|
| R | -CH2-O- | -CO-NH- | |||||
| ν CH2sym | ν CH2 asym | νC-O-Csym | νC-O-Casym | δ CH2 | ν C-N | ||
| -C6H5 | 2852.2 | 2921.7 | 1008.2 | 1243.0 | 1491.4 | 1553.6 | 1243.0 |
| -C6H4CH3 (4) | 2852.2 | 2921.7 | 1012.7 | 1243.9 | 1491.1 | 1550.6 | 1243.9 |
| -C6H4OCH3 (4) | 2829.0 | 2910.1 | 1036.6 | 1241.1 | 1488.5 | 1553.1 | 1241.1 |
| -C6H4Cl (4) | 2848.3 | 2929.4 | 1035.1 | 1243.1 | 1491.3 | 1554.3 | 1243.1 |
| -C6H3Cl2 (2,4) | 2856.0 | 2921.7 | 1036.0 | 1242.7 | 1491.5 | 1540.0 | 1242.7 |
| -C6H3Cl2 (2,5) | 2852.2 | 2921.7 | 1036.3 | 1243.6 | 1491.0 | 1552.7 | 1243.6 |
| -C6H3Cl2 (2,6) | 2856.0 | 2917.8 | 1036.5 | 1240.3 | 1486.9 | 1553.3 | 1240.3 |
| -C6H4Br (4) | 2852.2 | 2921.7 | 1033.4 | 1242.9 | 1490.5 | 1553.9 | 1242.9 |
| R | -CO-NH- | aromatic rings | -NH-CS-NH- | C-halogen | |||
| ν C=O | ν N-H | ν =CH | ν C=C | ν C=S | ν C-Cl | ν C-Br | |
| -C6H5 | 1682.9 | 3442.7 | 3018.1 | 1598.7 | 1166.7 | 749.5 | - |
| -C6H4CH3 (4) | 1683.5 | 3458.1 | 3029.7 | 1596.8 | 1164.0 | 749.1 | - |
| -C6H4OCH3 (4) | 1683.4 | 3436.9 | 3002.7 | 1598.6 | 1167.4 | 746.7 | - |
| -C6H4Cl (4) | 1679.8 | 3356.4 | 3029.7 | 1603.2 | 1151.4 | 744.2 | - |
| -C6H3Cl2 (2,4) | 1684.0 | 3381.1 | 3099.2 | 1584.2 | 1152.9 | 744.8 | - |
| -C6H3Cl2 (2,5) | 1679.1 | 3442.7 | 3025.9 | 1585.0 | 1168.2 | 751.6 | - |
| -C6H3Cl2 (2,6) | 1693.1 | 3439.4 | 3030.2 | 1597.8 | 1168.3 | 753.2 | - |
| -C6H4Br (4) | 1678.6 | 3360.7 | 3030.6 | 1600.7 | 1151.1 | 755.9 | 607.7 |
Qualitative antimicrobial activity screening
The qualitative method used for the screening of the antimicrobial activity for all tested compounds was an adaptation of the disk diffusion method (see Figure 1). The results correlated well with those of the quantitative antimicrobial activity assays.
Figure 1.
The aspect of inhibition zones obtained for the tested compounds on different pathogens in the qualitative screening assay by the adapted Kirby- Bauer method.
Figure 1.
The aspect of inhibition zones obtained for the tested compounds on different pathogens in the qualitative screening assay by the adapted Kirby- Bauer method.

Quantitative antimicrobial activity assay
The quantitative assay results for the antimicrobial activity of the new thioureides are presented in Table 6. These results show that the tested compounds exhibited a specific antimicrobial activity, depending on the nature of the substituents and their position on the benzene ring, both concerning the microbial spectrum and the MIC values, which ranged widely between 1024 and 32 μg/mL. The most active compounds proved to be N-[2-(4-chlorophenoxymethyl)-benzoyl]-N'-(2,6-dichlorophenyl)-thiourea (5g) and N-[2-(4-chlorophenoxymethyl)-benzoyl]-N'-(4-bromophenyl)-thiourea (5h), which showed a broad spectrum of antimicrobial activity against enterobacterial strains (E. coli and S. enteritidis), P. aeruginosa, S. aureus and Candida spp. All the tested compounds were highly active against S. aureus (MIC= 32 μg/mL), suggesting their possible use in the treatment of MRSA infections. Four of the tested compounds exhibited antifungal activity (MIC= 256-32 μg/mL), and L. monocitogenes as well as B. subtilis were resistant to all tested compounds.

Table 6.
The quantitative antibacterial and antifungal activity test results of the new thioureides and the respective MIC values.
| Organisms | Compounds | |||||||
|---|---|---|---|---|---|---|---|---|
| 5a | 5b | 5c | 5d | 5e | 5f | 5g | 5h | |
| E. coli | > 1024 | 32 | 32 | 32 | > 1024 | > 1024 | 256 | 128 |
| S. enteritidis | 256 | > 1024 | > 1024 | 32 | > 1024 | > 1024 | 128 | 128 |
| P. aeruginosa | > 1024 | > 1024 | > 1024 | > 1024 | > 1024 | > 1024 | 32 | 32 |
| L. monocytogenes | > 1024 | > 1024 | > 1024 | > 1024 | 512 | 512 | > 1024 | > 1024 |
| S. aureus | 32 | 32 | 32 | 32 | 32 | 256 | 32 | 32 |
| B. subtilis | > 1024 | > 1024 | 1024 | > 1024 | > 1024 | > 1024 | > 1024 | > 1024 |
| C. albicans | 256 | 64 | 512 | 512 | > 1024 | > 1024 | 32 | 32 |
Flow cytometry and annexin V assay
The cytotoxicity of the most active antimicrobial compounds, 5g and 5h, was tested with their possible use in much more in depth studies for the design of new antimicrobial chemical compounds in mind.

Table 7.
Cytotoxic effects of the 5g and 5h on HeLa cells quantified by flow cytometry assay.
| HeLa cells | ||||
|---|---|---|---|---|
| 1 (% necrosis) | 2 (% secondary necrosis) | 3 (% viable cells) | 4 (% apoptosis) | |
| Cell control | 3.42 | 0.70 | 95.00 | 0.19 |
| 5g | 13.89 | 9.10 | 84.00 | 0.15 |
| 5h | 6.77 | 0.70 | 95.00 | 0.15 |
The cytotoxicity assay has demonstrated that the two selected compounds exhibited low cytotoxicity levels, comparable to those obtained for the cell control (Table 7, Figure 2), demonstrating the possibility to be configured for the in vivo antimicrobial use.

Figure 2.
Flow cytometry dot-plots of effects on HeLa cells: a) Control; b) 5g; c) 5h.
Figure 2.
Flow cytometry dot-plots of effects on HeLa cells: a) Control; b) 5g; c) 5h.

Conclusions
In summary, our studies have demonstrated that among other biological activities, the thioureides of 2-(4-chlorophenoxymethyl)-benzoic acid also exhibit selective and effective antimicrobial properties that could lead to the selection and use of these compounds as efficient antimicrobial agents, especially for the treatment of multidrug resistant infections.
Experimental
General
The new compounds were prepared in three steps, as described above, and their physical properties and chemical structures further characterized and confirmed by elemental analysis, 1H-NMR, 13C-NMR and IR. All melting points were recorded with an Electrothermal 9100 apparatus and are uncorrected. Elemental analysis was realized using a Perkin Elmer CHNS/O Analyser Series II 2400 apparatus. The NMR spectra were recorded on a Gemini 300BB instrument, operating at 300 MHz for 1H and 75 MHz for 13C, using solutions in DMSO-d6 as solvent and tetramethylsilane as internal reference. The IR spectra were recorded using potassium bromide tablets on a Biorad FTS 135 apparatus.
Synthesis of 2-(4-chloro-phenoxymethyl)-benzoic acid (1)
A solution of freshly distilled p-chlorophenol (mol. wt. 128.61, 6.43 g, 0.05 mol) in xylene (30 mL) was placed in a round-bottomed flask equipped with a Dean-Stark trap device, then Subsequently, potassium hydroxide (mol. wt. 56.11, 3.10 g, 0.055 mol) was added. The reaction mixture was refluxed while the resulting water was removed by azeotropic distillation and potassium p-chloro-phenoxide precipitated. Phthalide (mol. wt. 134.14, 6.7 g, 0.05 mol) was added and the mixture was refluxed until it solidified. The precipitate was heated with 10% potassium hydroxide solution until id dissolved and it then was diluted with water. The aqueous phase was separated and acidulated (pH= 3) with 1M hydrochloric acid solution, whereupon the 2-(4-chlorophenoxymethyl)-benzoic acid (mol. wt. 262.687, 6.5 g, 49.6% yield) precipited. The precipitate was crystallized from water-ethanol (1: 3). It showed a m.p. of 167- 169°C.
Synthesis of 2-(4-chloro-phenoxymethyl)-benzoyl chloride (4)
2-(4-chlorophenoxymethyl)-benzoic acid (1, 5.25 g, 0.02 mol), dry 1,2-dichlorethane (30 mL) and thionyl chloride (mol. wt. 119, d420 1.6385 g/mL, 3 mL, 0.042 mol) were placed in a round-bottomed flask equipped with a condenser and drying tube. The mixture was refluxed for 3 hours. The excess thionyl chloride and the solvent were removed under reduced pressure and the crude acid was used directly in the next step.
General procedure for the synthesis of the new thioureides (5a)-(5h)
To a solution of ammonium thiocyanate (mol. wt. 76.13, 0.76 g, 0.01 mol, dried by heating at 100°C) in dry acetone (5 mL, dried over potassium carbonate) was added a solution of 2-(4-chlorophenoxymethyl)-benzoyl chloride (4, mol. wt. 281.39, 0.01 mol) in dry acetone (15 mL). The reaction mixture was refluxed one hour in a round-bottomed flask equipped with a condenser and a drying tube. After cooling, dry and freshly distilled primary aromatic amine (0.01 mol) in dry acetone (2 mL) were added by stirring, to the reaction mixture. The mixture was then refluxed for one hour. The product was precipitated after the cooled reaction mixture was poured into water (500 mL). The crude thioureides obtained were crystallised from isopropanol containing active carbon.
Microbial strains
The antimicrobial activity of the investigated compounds was tested against bacterial and fungal strains recently isolated from clinical specimens as well as reference strains belonging to the following genera and species: Gram positive (methicillin resistant Staphylococcus aureus, Listeria monocytogenes, Bacillus subtilis), Gram-negative (Escherichia coli, Salmonella enteritidis, Pseudomonas aeruginosa) and Candida albicans. The microbial strains were identified by aid of VITEK I automatic system. VITEK cards for identification and susceptibility testing (GNS-522) were inoculated and incubated according to the manufacturer's recommendations. The results were interpreted by using software version AMS R09.1. Bacterial suspensions of 1.5x108 CFU/mL or 0.5 McFarland density obtained from 15-18 h bacterial cultures developed on solid media were used in the experiments. The antimicrobial activity was tested on Mueller-Hinton medium recommended for the bacterial strains and Yeast Peptone Glucose (YPG) medium for Candida albicans. We used the solutions of the new compounds in DMSO with 2048 μg/ mL concentration. The cell cultures used in cytotoxicity assay were represented by HeLa (ECACC # 93021013) cells. The cells were grown in Dulbecco’s Modified Essential medium DMEM (Sigma) supplemented with 10 % fetal calf serum (Sigma) at 37°C, 5% CO2, in a humid atmosphere [5,6].
Qualitative screening of the antimicrobial properties of the tested compounds
The qualitative screening was performed by an adapted disk diffusion method. Petri dishes with Mueller Hinton (for bacterial strains)/YPG (for yeasts) media were seeded with bacterial inoculums as for the classical antibiotic susceptibility testing disk diffusion method (Kirby-Bauer); 5 mm diameter paper filter disks were placed on the seeded medium, at 30 mm distance. Subsequently, the disks were impregnated with 5 μL tested compound solution (1024 µg/mL concentration). The plates were left at room temperature for 20-30 minutes and then incubated at 37oC for 24 hrs. The positive results were read as the occurrence of an inhibition zone of microbial growth around the disk [7,8,9].
Quantitative assay of the antimicrobial activity
These tests were performed by the binary micro dilution method, in 96 multi-well plates, in order to establish the minimal inhibitory concentration (MIC) [10,11,12]. For this purpose, serial binary dilutions of the tested compounds (ranging between 1024 and 16 µg/ mL) were performed in a 200 μL volume of nutrient broth and each well was seeded with 50 μL microbial inoculum. The plates were incubated for 24 hrs at 37oC, and MICs were read as the lowest concentration of compound which inhibited the microbial growth.
Flow cytometry and annexin V assay
HeLa cells were grown in DMEM supplemented with 10% foetal calf serum (FCS) and 24 h later 5 μg/ml of the tested compound were added. Cells from the supernatant and monolayer were harvested and 1×105 cells were stained with annexin V and propidium iodide using the Immunotech Annexin V-FITC Kit (Beckman Coulter Company, France) following the manufacturer’s instructions. Cells were analyzed by flow cytometry using a Coulter EPICS XL flow cytometer (Beckman Coulter). Green fluorescence (525 nm; FITC annexin V) and red fluorescence (613 nm; propidium iodide) were measured. The experiment was repeated three times [5,6].
References
- Limban, C.; Missir, Al.; Chiriţă, I. Noi tioureide ale acidului 2-fenoximetil-benzoic. Nota I. Farmacia 2000, 6, 73–78. [Google Scholar]
- Limban, C.; Missir, Al.; Chiriţă, I. Noi tioureide ale acidului 2-fenoximetil-benzoic. Nota II. Farmacia 2004, 5, 7–12. [Google Scholar]
- Limban, C.; Missir, Al.; Chiriţă, I.; Missir, C. The synthesis and characterization of some new thioureides of 2-(4-methylphenoxymethyl)-benzoic acid with potential pharmacological activity. In Romanian International Conference on Chemistry and Chemical Engineering-RICCCE XIV, Bucarest, Rumania, 22-24 September 2005; Vol.4. S-02-99.
- Limban, C.; Chiriţă, I.; Missir, Al. Synthesis and characterization of some new thioureides of 2-(4-methoxyphenoxymethyl)-benzoic acid with potential pharmacological activity. TimisoaraMed. J. 2005, 55, 42–44. [Google Scholar]
- Mutiu, A.; Alexiu, I.; Chivu, M.; Petica, M.; Anton, G.; Bleotu, C.; Diaconu, C.; Popescu, C.; Jucu, V.; Cernescu, C. Detection of human papillomavirus gene sequence in cell lines derived from laryngeal tumors. J. Cell. Mol. Med. 2001, 5, 49–59. [Google Scholar] [CrossRef]
- Diaconu, C.; Bleotu, C.; Chivu, M.; Alexiu, A.; Petrusca, D.; Anton, G.; Achim, R.; Ruta, S.M.; Cernescu, C. The development of larger cells that spontaneously escape senescence - a step during the immortalization of a human cancer cell line. J. Cell. Mol. Med. 2004, 8, 93–101. [Google Scholar] [CrossRef]
- Olar, R.; Badea, M.; Cristurean, E.; Lazar, V.; Cernat, R.; Balotescu, M.C. Thermal behavior, spectroscopic and biological characterization of Co (II), Zn (II) and Pt (II) complexes with N,N-dimethylbiguanide. J. Therm. Anal. Calorim. 2005, 80, 451–455. [Google Scholar] [CrossRef]
- Lazar, V.; Balotescu, M.C.; Moldovan, L.; Vasilescu, G.; Petrache, L.M.; Bulai, D.; Cernat, R. Comparative evaluation of qualitative and quantitative methods used in the study of antifungal and antibacterial activity of hydroalcoholic vegetal extracts. Roum. Biotechnol. Lett. 2005, 10, 2225–2232. [Google Scholar]
- Balotescu, M.C.; Oprea, E.; Petrache, L.M.; Bleotu, C.; Lazar, V. Antibacterial, antifungal and cytotoxic activity of salvia officinalis essential oil and tinctures. Roum. Biotechnol. Lett. 2005, 10, 2481–2481. [Google Scholar]
- Clinical and Laboratory Standards Institute. Performance Standards for Antimicrobial Susceptibility Testing; Seventeenth Informational Supplement, M100-S17, Vol. 27 No. 1, Replaces M100-S16, Vol. 26 No. 3, Informational Supplement; CLSI: Wayne, PA, USA, 2007. [Google Scholar]
- Clinical and Laboratory Standards Institute. Methods for dilution antimicrobial susceptibility tests for bacteria that grow aerobically; Approved standard M7-A2; CLSI: Wayne, PA, USA, 1999. [Google Scholar]
- Balotescu, M.C.; Limban, C.; Missir, A.V.; Chirita, I.C.; Nitulescu, M.G. The Synthesis and Biological Activities Of Some New 2-(4-Methoxyphenoxymethyl)benzoic Acid Thioureides. Rev. Chim. (Bucuresti) 2007, 58, 1064–1068. [Google Scholar]
- Sample availability: Contact the authors.
© 2008 by MDPI (http://www.mdpi.org). Reproduction is permitted for noncommercial purposes.
